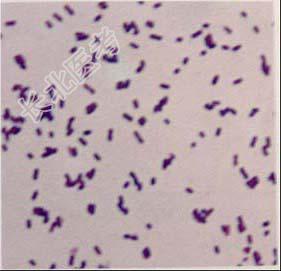

试题详情
- 单项选择题某细菌在血琼脂平板上生长时菌落细小、凸起,有光泽的革兰阳性杆菌, 菌体长短不一,触酶阴性, 分解葡萄糖、乳糖,精氨酸水解酶阳性, 动力阴性,抗酸阴性, TSI中产HS,该细菌可能是( )

A、红斑丹毒丝菌
B、产单核细胞李斯特菌
C、碳疽芽孢杆菌
D、马红球菌
E、以上均不是
关注下方微信公众号,搜题查看答案

热门试题
- 1、不能检测8 μg/ml VISA的方
- 在3%NaCl琼脂培养基上形成多形态的是
- 下列关于衣原体叙述正确的是( )A、
- 历次霍乱世界性大流行的病人多为儿童,提示
- 下列关于菌群的说法正确的是 ( )A、不
- 具有粘附作用的物质有 ( )A、
- 血平板上能形成双溶血环的细菌是A、肉毒梭
- 临床上可用于酵母菌鉴定的商品化试剂盒是A
- 下列血培养系统中哪一种既可检测普通细菌又
- 对人有致病性的链球菌主要是( )A、A
- 如果所示为细菌鞭毛的模式图,其中结构1~
- 1、该病可能的诊断为2、提示:若患儿病情
- 导致先天性畸形的常见病毒是( )A、E
- 检测HIV及其组分不适用于A、近期受HI
- 以下说法错误的是 ( )A、为提
- 丹毒丝菌属的鉴别特征是 ( )A
- 下列哪种病毒感染可致中枢神经系统感染 (
- 能引起感染性腹泻的细菌是A、志贺菌B、副
- 编码大肠菌素的质粒是( )A、Col质
- 大肠埃希菌O157的血清型应该表示为